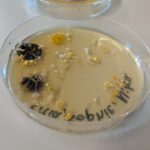
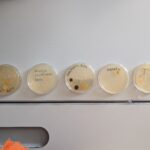
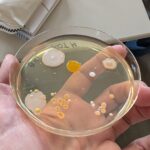
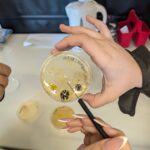

Wenige Tage nach der Beimpfung unserer Nährplatten mit den Biofilmen der Fingerkuppen konnten die SchülerInnen der 6a beobachten, wie diese wortwörtlich zu florieren begannen. Wir untersuchten Abstriche unter dem Lichtmikroskop und die SchülerInnen fertigten wissenschaftliche Zeichnungen an. Dass sich dieses Experiment nicht nur für die Mikrobiologie, sondern auch für Gender Studies eignet, zeigte die Tatsache, dass zwischen männlichen und weiblichen Fingerabdrücken deutlich sichtbare Unterschiede zu erkennen waren. Über die Ursache dessen darf spekuliert werden…
Ähnliche Beiträge
Young Mum – 6A zu Besuch bei der Hebamme
Die SchülerInnen der 6A hatten im Rahmen eines dreistündigen Vortrags von Simone Wimmer, Hebamme bei Young Mum im St. Josef Krankenhaus, die Gelegenheit, Fragen rund…
BiodiverCITY Island Hopping – Unsere erste Outdoor-Session
Ende April und Anfang Mai ging es im Rahmen unseres Sparkling-Science-Projekts BiodiverCITY Island Hopping zum ersten Mal ins Freie. Begleitet und betreut von ÖkologInnen der…
Ein Besuch der 2D in der Müllverbrennungsanlage Spittelau
Im Rahmen des Klimaaktionstags am 23.04.2025 besuchte die Klasse 2D die Müllverbrennungsanlage Spittelau. Der Tag begann mit einem gemeinsamen, gesunden Frühstück in der Klasse, bevor…
Sparkling Science – Frühjahrspflanzung
Etwas chaotisch ging es heute im Wahlpflichtfach Biologie bei unserer ersten eigenen Pflanzung für das Sparkling Science Projekt BiodiverCITY Island hopping zu. Eigentlich war es…
Sparkling Science – BiodiverCITY Island Hopping – Kick Off am Unicampus
Mit dem heurigen Schuljahr nimmt die Erlgasse am Sparkling Science Projekt „BiodiverCITY Island Hopping“ teil. Am 18.03. fand hierfür eine große Kick Off Veranstaltung für…
A schene Leich – Besuch der Michaeler Gruft im Wahlpflichtfach Biologie
Wie amüsant – vorausgesetzt man mag es ein bisschen makaber – eine Gruftführung sein kann, durften die SchülerInnen des Biowahlpflichtfachs mit Prof. Seidl samt Gästen…